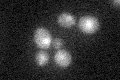
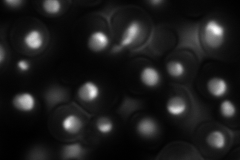

View description
Essential protein of unknown function; heterozygous mutant shows haploinsufficiency in K1 killer toxin resistance
Localization:
Intensity:
Fold change:
Significance:
-
C’ GFP library in SD
nucleus19.89 -
N' NOP1pr-GFP in SD
nucleus,nucleolus226.491 -
N' TEF2pr-mCherry in SD

cell periphery,vacuole223.47 -
N' NATIVEpr-GFP in SD

nucleus,nucleolus107.614 -
N' TEF2pr-VC and Cyto-VN in SD

#N/A0 -
C’ GFP library in SD+DTT

nucleus19.150.96No -
C’ GFP library in SD+H2O2

nucleus22.861.14No -
C’ GFP library in Starvation Media

nucleus18.920.95No -
C’ GFP library on the background of Pup2-DaMP

nucleus -
C’ GFP library on the background of CCT mutant

nucleus23.82851.19737No
